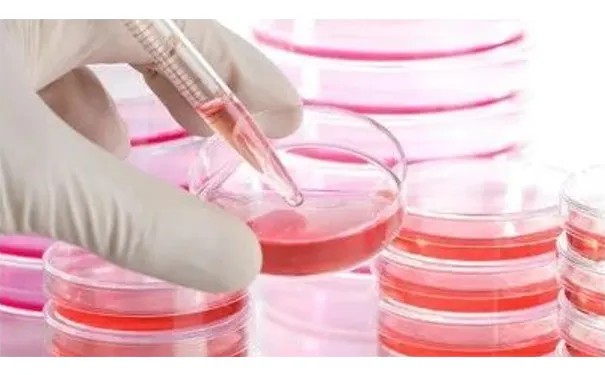
杭州博养压疮治疗中心

发布时间:2026-01-05 浏览量:0
下肢静脉曲张性溃疡是由于静脉血液淤积引起的局部皮部皮肤营养不良造成的,称静脉性溃疡。
下肢静脉系统淤血造成静脉系统高压,可以逆向破坏交通静脉中的瓣膜,使深静脉中的血液经交通静脉反向流入浅静脉,并淤聚于踝上皮下的静脉网中,长期后因局部组织缺氧,终于导致踝部(尤其是内踝)的皮肤障碍病变,如皮炎,湿疹,色素沉着等,严重者发生溃疡形成,这些溃疡可为单发,也有的多发;有的长期不愈,有些则反复发作。
那么如何治疗下肢静脉曲张性溃疡呢?这期来为大家讲述下肢静脉性溃疡的治疗。
大多数踝部溃疡的病因,是深静脉高压使交通静脉发生倒流所致。经报道,下肢慢性静脉功能不全临床症状发生率为:无可见或可触及的静脉疾病体征占19.1%,毛细血管,网状静脉扩张占36.7%,静脉曲张占27.0%,静脉曲张伴水肿占10.0%,继发皮肤和皮下组织改变占6.3%,皮肤改变已愈合的静脉性溃疡占 0.6%,皮肤改变未愈合的静脉性溃疡占0.2%。

解决深静脉反流是手术治疗的关键。采用各种方法彻底结扎或切断功能不全的交通静脉是必不可少的。
大隐静脉高位结扎剥脱术是治疗下肢静脉曲张的传统手术,目前许多专著中仍要求腹股沟处切口长6cm以上,结扎大隐静脉的5个属支,有血管床损伤较大,切口多,术后恢复周期长,影响肢体美观和复发率高等不足。随着医学技术的进步,出现了多种微创治疗大隐静脉曲张的方法,常见的有:静脉腔内激光闭合术,静脉腔内射频消融闭合术以及静脉腔内电凝术等,都有其相应的手术适应证及优缺点。

大隐静脉有5大属支,旋髂浅静脉,腹壁浅静脉及阴部外静脉属支一般很少发生曲张,保留这支浅表静脉可充分保证局部的血液回流并在患者发生某些疾病,如髂股静脉血栓或门静脉高压症时发挥旁路作用。所以研究人员在传统手术的基础上加以改进,于腹股沟处采用1cm左右的小切口高位结扎大隐静脉,内踝处1cm小切口,用微创剥脱器剥脱全长大隐静脉主干,术前标记的曲张静脉团用电凝针电凝,可以缩小并减少切口,小切口均采用输液黏合贴黏合,没有缝线,减少了瘢痕的发生,不用拆线具有美腿的效果;缩短了住院时间,降低了住院费用。手术中节省了寻找和处理旋髂浅,腹壁浅以及阴部外静脉属支的时间,同时减小了手术创伤。

1 静脉剥脱器自踝部向上插人,与静脉瓣方向一致,易于顺利插人。
2 剥脱器头端抵达腹股沟时,可作为腹股沟切口的标记,又可以其为指引找到大隐静脉及其分支,不致误伤股静脉,也不致将较粗的分支当成大隐静脉主干而致术后复发。
3 剥脱器插入大隐静脉主干在剥脱前,先用自制电凝针电凝闭锁术前标记又可以其为指引找到大隐静脉及其分支,不致误伤股静脉,
也不致将较粗的分支当成大隐静脉主干而致术后复发。
4 大隐静脉主干置入剥脱器后,先用弹力绷带加压包扎下肢,然后抽剥大隐静脉主干,主干抽剥后,创面即处于加压包扎状态下,使主干与小分支断裂处及静脉床不出血,避免了皮下淤血,出血,血肿的发生。
5 因为术前检查排除了深静脉血栓和深静脉瓣膜功能不全的存在,所有曲张的浅静脉均被剥脱,且剥脱时破坏了深浅静脉交通支,同时结合电凝术前标记的曲张静脉团及交通支静脉,术后复发率低,保证了疗效。
在正确掌握手术适应证和手术要点的前提下,采用大隐静脉高位结扎微创剥脱加电凝术是一个实用,有效,微创的手术方法。
硬化治疗是指通过选择性向病变静脉内注射硬化剂,使静脉管壁继发无菌性炎症反应,术后持续压迫使静脉萎陷,肉芽组织继之之纤维化在萎陷的静脉腔内生长,最终形成纤维索条,达到治疗静脉曲张和静脉畸形的目的。
1963年Henschel首次报道应用聚桂醇进行硬化化治疗。之后研究者们致力于硬化疗法的改进和制作泡沫硬化剂的技术。

泡沫硬化剂是指把液体硬化剂与气体混合而形成成的新型泡沫状硬化剂物质。
同液体硬化剂相比,泡沫硬化剂的优点:
1.泡沫硬化剂注人静脉后呈团状,阻止了血液对药物的稀释,减缓了血流速度,药物对内皮细胞作用时间延长;给静脉血管留下足够的收缩空间,硬化闭塞后更为满意;
2.便于彩超监视,以提高治疗的安全性;
3.泡沫可被组织很好很快地吸收;
4.药物的流动性使之能到达曲张静脉各部位;
5.药物在血管腔内的作用避免了血管外的神经损伤。
泡沫硬化剂以其高效,安全,快捷的特点,成为治疗静脉曲张和静脉畸形的主要方法之一。

从硬化剂的注射方式看,以静脉回流方向来看,可分为顺行注射和逆行注射。顺行注射在未阻断静脉血流的情况下,可以跨越功能正常和异常的瓣膜阻挡,扩散较远,较易沿着交通支到达深静脉,引起肺动脉栓塞。
逆行注射优点:
1 由于近心端静脉相对较粗,穿刺较容易;
2 向远心端注射没有如顺行注射时进入深静脉肺动脉气栓的顾虑大,注射速度可稍快一些;
3 正常的瓣膜可阻挡硬化剂向远处扩散,而异常瓣膜则不能阻挡向远处扩散,因此逆行注射可有选择性地保护正常静脉血管。

经分析显示超声引导下使用泡沫硬化剂治疗下肢静脉曲张的效果可与外科手术相媲美。研究显示,术后6个月,泡沫硬化治疗的疗效甚至优于外科手术治疗。从远期效果看,泡沫硬化治疗的3年成功率可达77%。
下肢静脉功能不全是高发的良性血管病变,溃疡是其严重并发症之一。传统手术及硬化治疗均可以获得较好的临床疗效。改善患者预后。
以上是有关下肢静脉性溃疡的手术治疗方法,下期将继续为大家讲述糖尿病足治疗相关的内容。